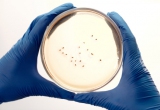

Noderīgi
- ZM reģionālās konferences par aktuālo nozarē 2025
- Tālmācība
- Konferences 2020-2025 ieraksti
- informatīvie izdevumi
- LEADER
- Skābbarības konkurss 2025
- ZM semināri 2024 par aktuālo nozarē un Latvijas KLP SP ieviešanā
- Zaļā kursa lauksaimniecības ceļvedis
- Makšķerēšanas kartes
- Lauksaimniecības demonstrējumu un izmēģinājumu datu bāze
- Lauksaimniecības tehnikas katalogs
- Piena pašizmaksas aprēķina modelis
- ES atbalsta pieejamības noteikšanas programma
- Palīgs ekonomiski pamatotas investīcijas veikšanas noteikšanai
- Tehnikas izmaksu aprēķins
- Racionālu piena lopkopības ražošanas modeļu rokasgrāmata
- Lopbarības analīžu rezultātu apkopojums
- Informatīvs materiāls par slaucamo govju fermu būvniecību